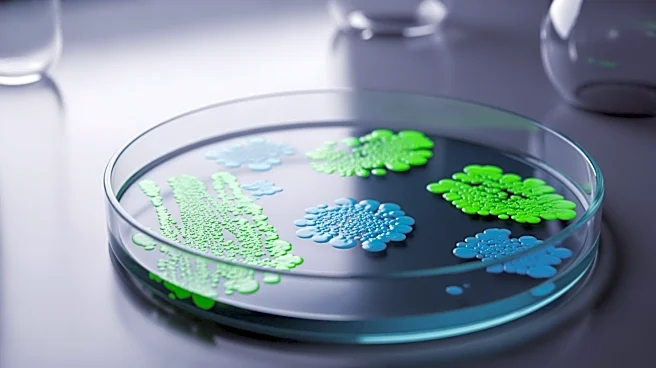
Bacteria from Frog Gut Shows Promise in Eradicating Tumors in Mice

What's Happening?
A study published in Nature reveals that apoptotic modulators can enhance the efficacy of oncolytic viruses in treating acute myeloid leukemia (AML). The research demonstrates that combining oncolytic viruses with SMAC and BH3 mimetics can increase cytokine-mediated
cell death in AML cells. This combination therapy leverages the inflammatory response induced by oncolytic viruses to potentiate the killing of cancer cells, offering a promising new strategy for AML treatment.
Why It's Important?
This development is crucial as it provides a potential new treatment option for AML, a type of cancer with limited therapeutic options and a high mortality rate. By enhancing the effectiveness of oncolytic viruses, this approach could improve patient outcomes and offer a more targeted treatment strategy. The study also highlights the potential of combining different therapeutic modalities to overcome the limitations of existing treatments.
What's Next?
Further research is needed to optimize the combination of oncolytic viruses and apoptotic modulators for clinical use. Clinical trials will be necessary to evaluate the safety and efficacy of this approach in patients with AML. Additionally, researchers will need to explore the potential of this combination therapy in other types of cancer, potentially broadening its applicability and impact.